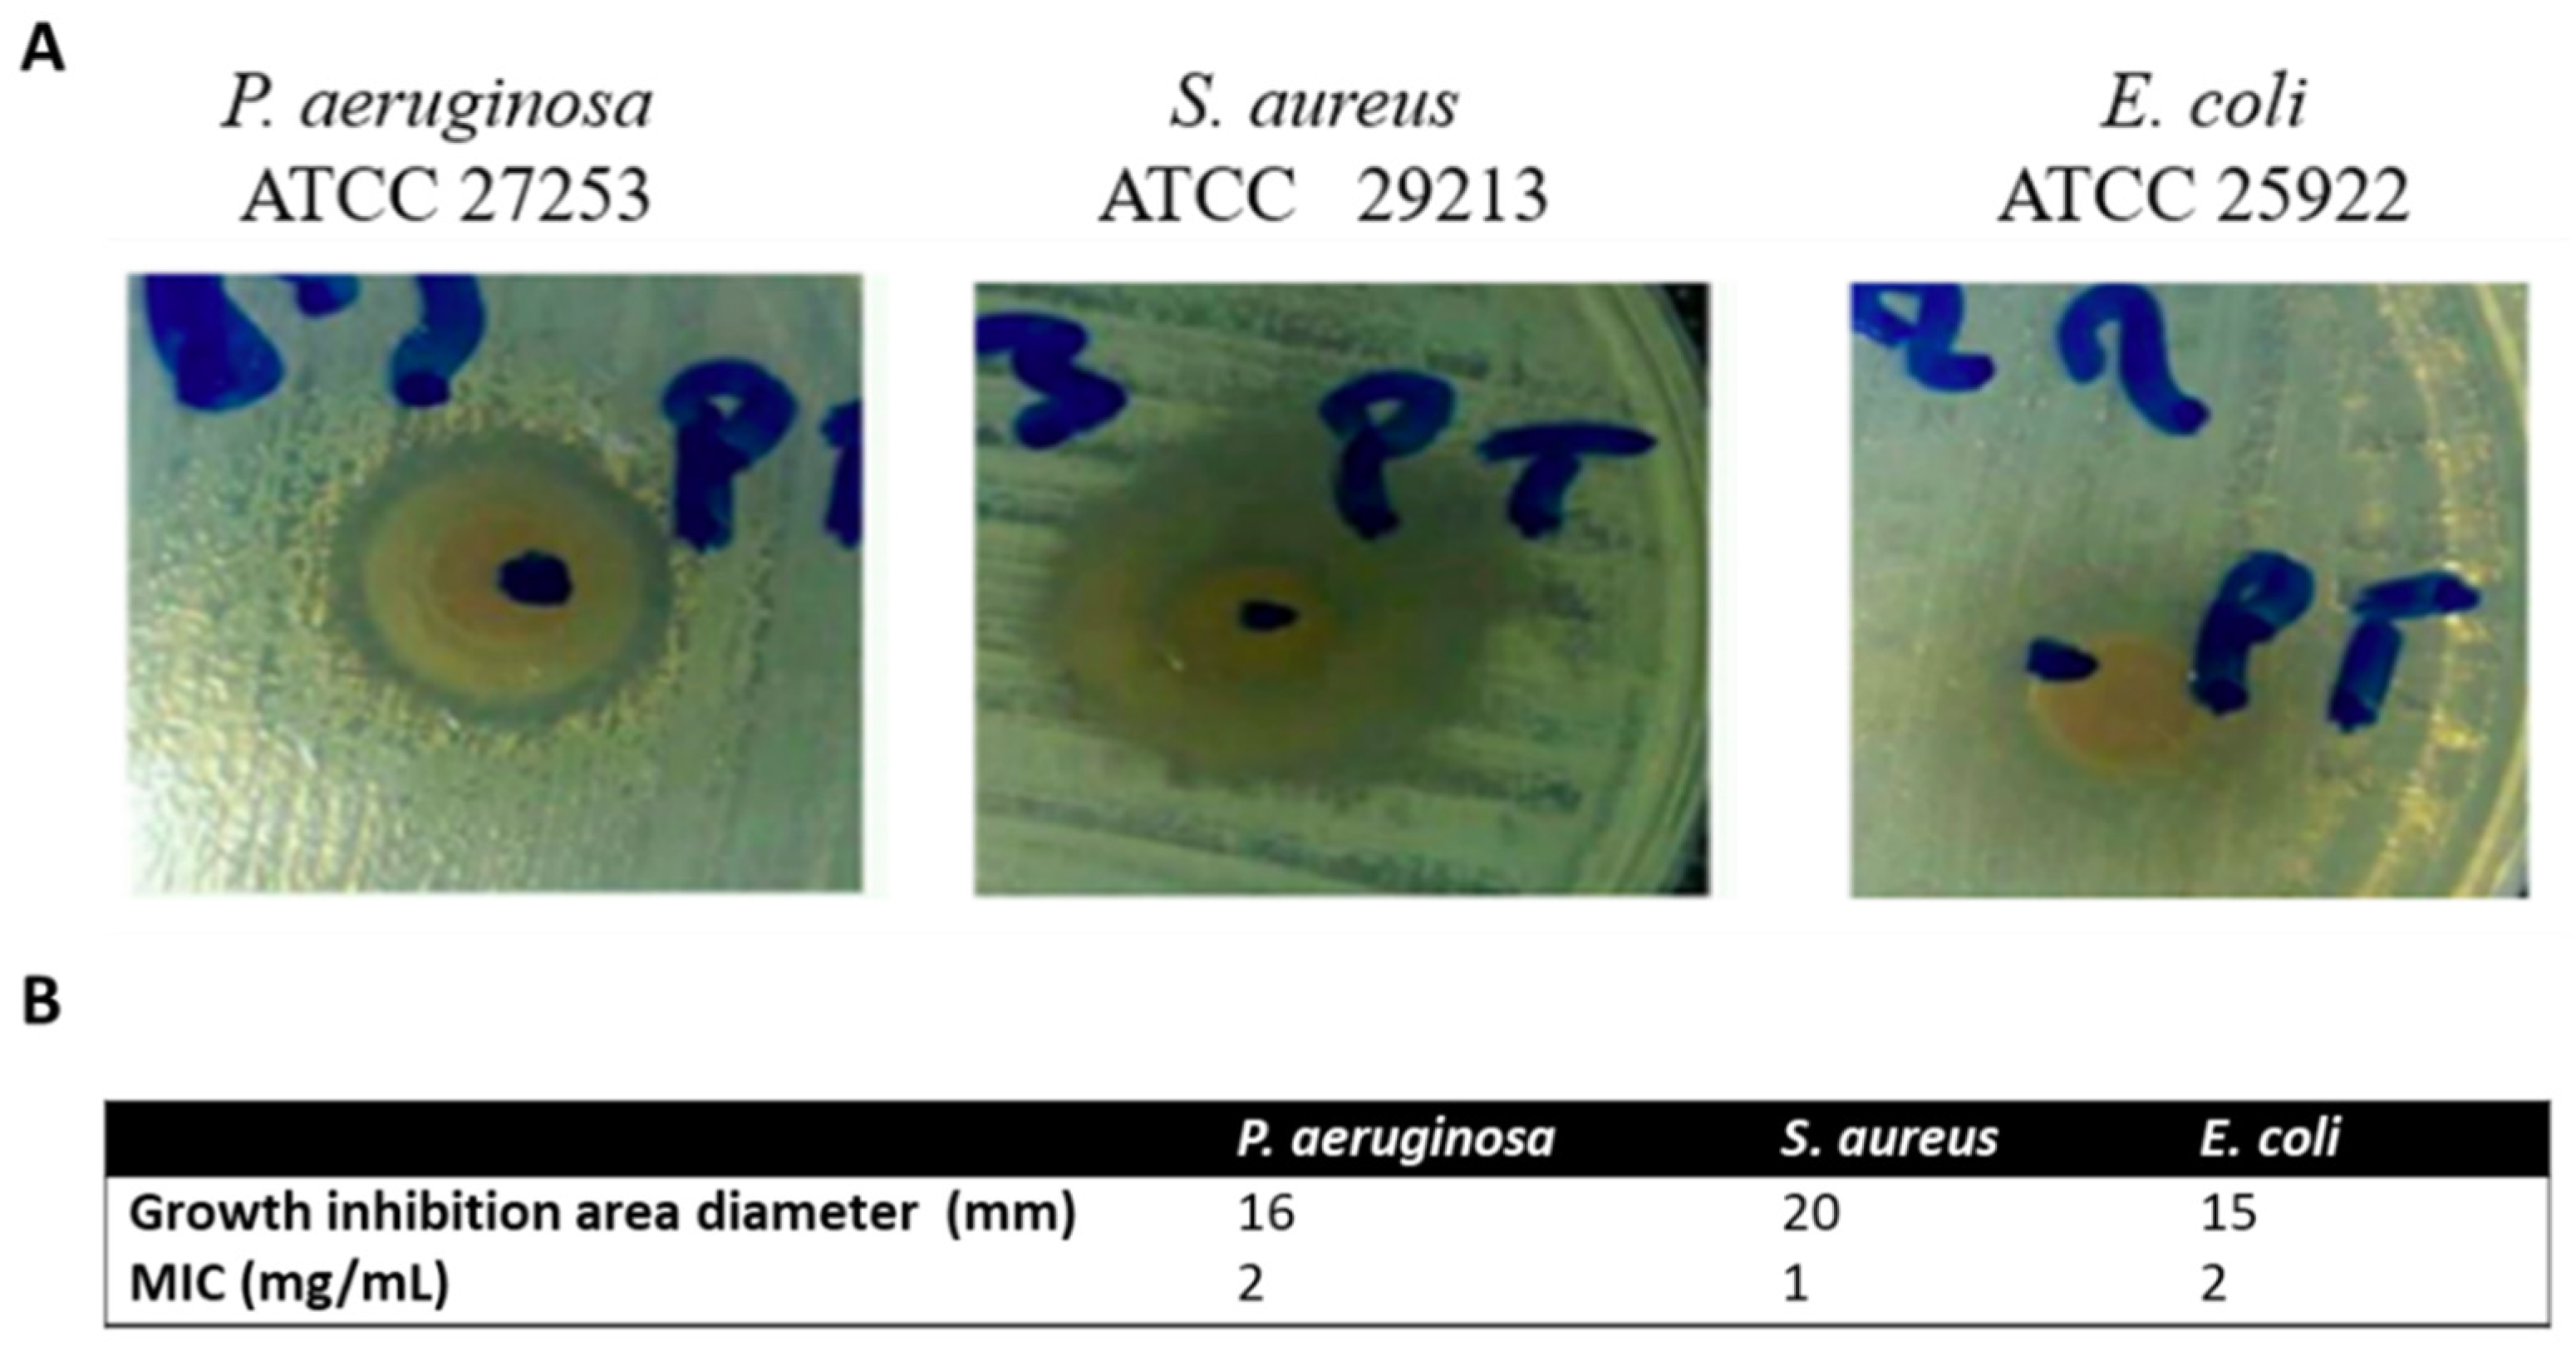

Biological Investigation of Amaryllidaceae Alkaloid Extracts from the Bulbs of Pancratium trianthum Collected in the Senegalese Flora
Abstract
1. Introduction
2. Results
2.1. Species Phylogenetic Analysis
2.2. Phytochemical Analysis
2.3. In Vitro Anti-AChE Activity
2.4. Cytotoxicity Activity
2.5. Antibacterial Activity
2.6. Antiviral Activity
2.7. Pro-Inflammatory Activity
3. Discussion
4. Materials and Methods
4.1. Plant Materials, Chemicals, and Species Identification
4.2. Crude Alkaloids Extraction and TLC Analysis
4.3. HPLC-PDA and GC-MS Analysis of Alkaloid Extracts
4.4. In Vitro Acetylcholinesterase (AChE) Inhibition Assay
4.5. Cell Lines
4.6. Cytotoxicity Assay
4.7. Bacteria and Viruses
4.8. Agar Diffusion Assay
4.9. Broth Dilution Method for Determination of Minimal Inhibitory Concentration (MIC)
4.10. In Vitro DENVGFP Infectivity Assay
4.11. In Vitro Pseudotyped HIV-1GFP Infectivity Assay
4.12. In Vitro Proinflammatory Assay
5. Conclusions
Author Contributions
Funding
Institutional Review Board Statement
Informed Consent Statement
Data Availability Statement
Acknowledgments
Conflicts of Interest
Sample Availability
Appendix A

References
- Jin, Z.; Yao, G. Amaryllidaceae and Sceletium alkaloids. Nat. Prod. Rep. 2019, 36, 1462–1488. [Google Scholar] [CrossRef] [PubMed]
- Nair, J.J.; Bastida, J.; Codina, C.; Viladomat, F.; van Staden, J. Alkaloids of the South African Amaryllidaceae: A review. Nat. Prod. Commun. 2013, 8, 1934578X1300800938. [Google Scholar] [CrossRef]
- Meerow, A.; Snijman, D. Amaryllidaceae. In Flowering Plants·Monocotyledons; Springer: Berlin/Heidelberg, Germany, 1998; pp. 83–110. [Google Scholar]
- Kerharo, J.; Bouquet, A. Plantes médicinales et toxiques de la Côte d’Ivoire-Haute-Volta: Mission d’étude de la pharmacopée indigène en AOF; Editions Vigot: Paris, France, 1950; 297p. [Google Scholar]
- Kerharo, J.; Adam, J.-G. La pharmacopée sénégalaise traditionnelle: Plantes médicinales et toxiques; Editions Vigot frères: Paris, France, 1974; 1011p. [Google Scholar]
- Kornienko, A.; Evidente, A. Chemistry, biology, and medicinal potential of narciclasine and its congeners. Chem. Rev. 2008, 108, 1982–2014. [Google Scholar] [CrossRef]
- Cahlíková, L.; Benesová, N.; Macákova, K.; Urbanová, K.; Opletal, L. GC/MS analysis of three Amaryllidaceae species and their cholinesterase activity. Nat. Prod. Commun. 2011, 6, 1255–1258. [Google Scholar] [CrossRef]
- Cheesman, L.; Nair, J.J.; van Staden, J. Antibacterial activity of crinane alkaloids from Boophone disticha (Amaryllidaceae). J. Ethnopharmacol. 2012, 140, 405–408. [Google Scholar] [CrossRef] [PubMed]
- Havelek, R.; Seifrtova, M.; Kralovec, K.; Bruckova, L.; Cahlikova, L.; Dalecka, M.; Vavrova, J.; Rezacova, M.; Opletal, L.; Bilkova, Z. The effect of Amaryllidaceae alkaloids haemanthamine and haemanthidine on cell cycle progression and apoptosis in p53-negative human leukemic Jurkat cells. Phytomed. Int. J. Phytother. Phytopharm. 2014, 21, 479–490. [Google Scholar] [CrossRef] [PubMed]
- Habartová, K.; Cahlíková, L.; Řezáčová, M.; Havelek, R. The Biological Activity of Alkaloids from the Amaryllidaceae: From Cholinesterases Inhibition to Anticancer Activity. Nat. Prod. Commun. 2016, 11, 1587–1594. [Google Scholar] [CrossRef]
- Cahlíková, L.; Vaněčková, N.; Šafratová, M.; Breiterová, K.; Blunden, G.; Hulcová, D.; Opletal, L. The Genus Nerine Herb. (Amaryllidaceae): Ethnobotany, Phytochemistry, and Biological Activity. Molecules 2019, 24, 4238. [Google Scholar] [CrossRef] [PubMed]
- Hulcova, D.; Marikova, J.; Korabecny, J.; Hostalkova, A.; Jun, D.; Kunes, J.; Chlebek, J.; Opletal, L.; De Simone, A.; Novakova, L.; et al. Amaryllidaceae alkaloids from Narcissus pseudonarcissus L. cv. Dutch Master as potential drugs in treatment of Alzheimer’s disease. Phytochemistry 2019, 165, 112055. [Google Scholar] [CrossRef] [PubMed]
- Al Shammari, L.; Al Mamun, A.; Koutová, D.; Majorošová, M.; Hulcová, D.; Šafratová, M.; Breiterová, K.; Maříková, J.; Havelek, R.; Cahlíková, L. Alkaloid profiling of Hippeastrum cultivars by GC-MS, isolation of Amaryllidaceae alkaloids and evaluation of their cytotoxicity. Rec. Nat. Prod. 2020, 14, 154–159. [Google Scholar] [CrossRef]
- Cahlíková, L.; Breiterová, K.; Opletal, L. Chemistry and Biological Activity of Alkaloids from the Genus Lycoris (Amaryllidaceae). Molecules 2020, 25, 4797. [Google Scholar] [CrossRef]
- Koutová, D.; Maafi, N.; Havelek, R.; Opletal, L.; Blunden, G.; Řezáčová, M.; Cahlíková, L. Chemical and Biological Aspects of Montanine-Type Alkaloids Isolated from Plants of the Amaryllidaceae Family. Molecules 2020, 25, 2337. [Google Scholar] [CrossRef]
- Marikova, J.; Mamun, A.A.; Shammari, L.A.; Korabecny, J.; Kucera, T.; Hulcova, D.; Kunes, J.; Malanik, M.; Vaskova, M.; Kohelova, E.; et al. Structure Elucidation and Cholinesterase Inhibition Activity of Two New Minor Amaryllidaceae Alkaloids. Molecules 2021, 26, 1279. [Google Scholar] [CrossRef]
- Ba, D. Le Pancratium trianthum. Available online: http://seyilaabe-htkm.blogspot.com/2015/10/ (accessed on 25 November 2020).
- Ioset, J.-R.; Marston, A.; Gupta, M.P.; Hostettmann, K. A methylflavan with free radical scavenging properties from Pancratium littorale. Fitoterapia 2001, 72, 35–39. [Google Scholar] [CrossRef]
- Sanaa, A.; Boulila, A.; Bejaoui, A.; Boussaid, M.; Fadhel, N.B. Variation of the chemical composition of floral volatiles in the endangered Tunisian Pancratium maritimum L. populations (Amaryllidaceae). Ind. Crops Prod. 2012, 40, 312–317. [Google Scholar] [CrossRef]
- Berhaut, J. Flora of Senegal; Editions Clairafrique: Dakar, Senegal, 1967; 485p. [Google Scholar]
- Schultes, E.R. Atlas des Plantes Hallucinogènes du Monde; Editions de l’Aurore: Montréal, QC, Canada, 1978; 112p. [Google Scholar]
- Monteil, V. Contribution à l’étude de la flore du Sahara occidental II. Institut des Hautes Etudes Marocaines; Notes Documents VI; Éditions Larose: Paris, France, 1953; 120p. [Google Scholar]
- Desgagne-Penix, I. Biosynthesis of alkaloids in Amaryllidaceae plants: A review. Phytochem. Rev. 2021, 20, 409–431. [Google Scholar] [CrossRef]
- Ka, S.; Merindol, N.; Koirala, M.; Desgagne-Penix, I. Biosynthesis and biological activities of newly discovered Amaryllidaceae alkaloids. Molecules 2020, 25, 4901. [Google Scholar] [CrossRef]
- Hotchandani, T.; Desgagne-Penix, I. Heterocyclic Amaryllidaceae Alkaloids: Biosynthesis and Pharmacological Applications. Curr. Top. Med. Chem. 2017, 17, 418–427. [Google Scholar] [CrossRef]
- Heinrich, M. Galanthamine from Galanthus and other Amaryllidaceae–chemistry and biology based on traditional use. In The Alkaloids: Chemistry and Biology; Elsevier: Amsterdam, The Netherlands, 2010; Volume 68, pp. 157–165. [Google Scholar]
- Naidoo, D.; Roy, A.; Slavětínská, L.P.; Chukwujekwu, J.C.; Gupta, S.; Van Staden, J. New role for crinamine as a potent, safe and selective inhibitor of human monoamine oxidase B: In vitro and in silico pharmacology and modeling. J. Ethnopharmacol. 2020, 248, 112305. [Google Scholar] [CrossRef]
- Ka, S.; Merindol, N.; Sow, A.A.; Singh, A.; Landelouci, K.; Plourde, M.B.; Pépin, G.; Masi, M.; Di Lecce, R.; Evidente, A.; et al. Amaryllidaceae alkaloid cherylline inhibits the replication of dengue and Zika viruses. Antimicrob. Agents Chemother. 2021, 65, e0039821. [Google Scholar] [CrossRef]
- Ka, S.; Masi, M.; Merindol, N.; Di Lecce, R.; Plourde, M.B.; Seck, M.; Gorecki, M.; Pescitelli, G.; Desgagne-Penix, I.; Evidente, A. Gigantelline, gigantellinine and gigancrinine, cherylline- and crinine-type alkaloids isolated from Crinum jagus with anti-acetylcholinesterase activity. Phytochemistry 2020, 175, 112390. [Google Scholar] [CrossRef]
- Cedrón, J.C.; Del Arco-Aguilar, M.; Estévez-Braun, A.; Ravelo, Á.G. Chemistry and biology of Pancratium alkaloids. In The Alkaloids: Chemistry and Biology; Elsevier: Amsterdam, The Netherlands, 2010; Volume 68, pp. 1–37. [Google Scholar]
- Frederik, D.M.; Murav’eva, D. Alkaloid composition of Pancratium trianthum. Chem. Nat. Compd. 1983, 18, 510. [Google Scholar] [CrossRef]
- Chapter 1 Occurrence of Alkaloids in Plant Species. Chem. Nat. Compd. 1996, 32, 104–173. [CrossRef]
- De Castro, O.; Brullo, S.; Colombo, P.; Jury, S.; De Luca, P.; Di Maio, A. Phylogenetic and biogeographical inferences for Pancratium (Amaryllidaceae), with an emphasis on the Mediterranean species based on plastid sequence data. Bot. J. Linn. Soc. 2012, 170, 12–28. [Google Scholar] [CrossRef][Green Version]
- Dereeper, A.; Guignon, V.; Blanc, G.; Audic, S.; Buffet, S.; Chevenet, F.; Dufayard, J.-F.; Guindon, S.; Lefort, V.; Lescot, M. Phylogeny. fr: Robust phylogenetic analysis for the non-specialist. Nucleic Acids Res. 2008, 36 (Suppl. 2), W465–W469. [Google Scholar] [CrossRef]
- Tallini, L.R.; Andrade, J.P.; Kaiser, M.; Viladomat, F.; Nair, J.J.; Zuanazzi, J.A.S.; Bastida, J. Alkaloid Constituents of the Amaryllidaceae Plant Amaryllis belladonna L. Molecules 2017, 22, 1437. [Google Scholar] [CrossRef]
- Trujillo-Chacón, L.M.; Pastene-Navarrete, E.R.; Bustamante, L.; Baeza, M.; Alarcón-Enos, J.E.; Cespedes-Acuña, C.L. In vitro micropropagation and alkaloids analysis by GC–MS of Chilean Amaryllidaceae plants: Rhodophiala pratensis. Phytochem. Anal. 2020, 31, 46–56. [Google Scholar] [CrossRef]
- López, S.; Bastida, J.; Viladomat, F.; Codina, C. Acetylcholinesterase inhibitory activity of some Amaryllidaceae alkaloids and Narcissus extracts. Life Sci. 2002, 71, 2521–2529. [Google Scholar] [CrossRef]
- Houghton, P.J.; Ren, Y.; Howes, M.-J. Acetylcholinesterase inhibitors from plants and fungi. Nat. Prod. Rep. 2006, 23, 181–199. [Google Scholar] [CrossRef]
- Houghton, P.J.; Agbedahunsi, J.M.; Adegbulugbe, A. Choline esterase inhibitory properties of alkaloids from two Nigerian Crinum species. Phytochemistry 2004, 65, 2893–2896. [Google Scholar] [CrossRef]
- Orhan, I.; Sener, B. Bioactivity-directed fractionation of alkaloids from some Amaryllidaceae plants and their anticholinesterase activity. Chem. Nat. Compd. 2003, 39, 383–386. [Google Scholar] [CrossRef]
- Soltan, M.M.; Hamed, A.R.; Hetta, M.H.; Hussein, A.A. Egyptian Pancratium maritimum L. flowers as a source of anti-Alzheimer’s agents. Bull. Fac. Pharm. Cairo Univ. 2015, 53, 19–22. [Google Scholar] [CrossRef][Green Version]
- Lamoral-Theys, D.; Andolfi, A.; Van Goietsenoven, G.; Cimmino, A.; Le Calvé, B.; Wauthoz, N.; Mégalizzi, V.; Gras, T.; Bruyère, C.; Dubois, J. Lycorine, the main phenanthridine Amaryllidaceae alkaloid, exhibits significant antitumor activity in cancer cells that display resistance to proapoptotic stimuli: An investigation of structure−activity relationship and mechanistic insight. J. Med. Chem. 2009, 52, 6244–6256. [Google Scholar] [CrossRef]
- Lamoral-Theys, D.; Decaestecker, C.; Mathieu, V.; Dubois, J.; Kornienko, A.; Kiss, R.; Evidente, A.; Pottier, L. Lycorine and its derivatives for anticancer drug design. Mini-Rev. Med. Chem. 2010, 10, 41–50. [Google Scholar] [CrossRef]
- Bonvicini, F.; Antognoni, F.; Iannello, C.; Maxia, A.; Poli, F.; Gentilomi, G.A. Relevant and selective activity of Pancratium illyricum L. against Candida albicans clinical isolates: A combined effect on yeast growth and virulence. BMC Complement. Altern. Med. 2014, 14, 409. [Google Scholar] [CrossRef]
- Adesanya, S.; Olugbade, T.; Odebiyl, O.; Aladesanmi, J. Antibacterial alkaloids in Crinum jagus. Int. J. Pharmacogn. 1992, 30, 303–307. [Google Scholar] [CrossRef]
- Tan, C.-X.; Schrader, K.K.; Mizuno, C.S.; Rimando, A.M. Activity of lycorine analogues against the fish bacterial pathogen Flavobacterium columnare. J. Agric. Food Chem. 2011, 59, 5977–5985. [Google Scholar] [CrossRef]
- Evidente, A.; Andolfi, A.; Abou-Donia, A.H.; Touema, S.M.; Hammoda, H.M.; Shawky, E.; Motta, A. (−)-Amarbellisine, a lycorine-type alkaloid from Amaryllis belladonna L. growing in Egypt. Phytochemistry 2004, 65, 2113–2118. [Google Scholar] [CrossRef]
- UNAIDS. Country Factsheets SENEGAL. 2020. Available online: https://www.unaids.org/sites/default/files/media_asset/2020_aids-data-book_en.pdf (accessed on 3 November 2021).
- Peng, X.; Sova, P.; Green, R.R.; Thomas, M.J.; Korth, M.J.; Proll, S.; Xu, J.; Cheng, Y.; Yi, K.; Chen, L. Deep sequencing of HIV-infected cells: Insights into nascent transcription and host-directed therapy. J. Virol. 2014, 88, 8768–8782. [Google Scholar] [CrossRef]
- Szlavik, L.; Gyuris, A.; Minarovits, J.; Forgo, P.; Molnar, J.; Hohmann, J. Alkaloids from Leucojum vernum and antiretroviral activity of Amaryllidaceae alkaloids. Planta Med. 2004, 70, 871–873. [Google Scholar] [CrossRef] [PubMed]
- Abd Kadir, S.L.; Yaakob, H.; Zulkifli, R.M. Potential anti-dengue medicinal plants: A review. J. Nat. Med. 2013, 67, 677–689. [Google Scholar] [CrossRef]
- Wang, P.; Li, L.F.; Wang, Q.Y.; Shang, L.Q.; Shi, P.Y.; Yin, Z. Anti-dengue-virus activity and structure–activity relationship studies of lycorine derivatives. ChemMedChem 2014, 9, 1522–1533. [Google Scholar] [CrossRef]
- Chen, H.; Lao, Z.; Xu, J.; Li, Z.; Long, H.; Li, D.; Lin, L.; Liu, X.; Yu, L.; Liu, W.; et al. Antiviral activity of lycorine against Zika virus in vivo and in vitro. Virology 2020, 546, 88–97. [Google Scholar] [CrossRef]
- Zou, G.; Puig-Basagoiti, F.; Zhang, B.; Qing, M.; Chen, L.; Pankiewicz, K.W.; Felczak, K.; Yuan, Z.; Shi, P.-Y. A single-amino acid substitution in West Nile virus 2K peptide between NS4A and NS4B confers resistance to lycorine, a flavivirus inhibitor. Virology 2009, 384, 242–252. [Google Scholar] [CrossRef] [PubMed]
- de Andrade, J.P.; Guo, Y.; Font-Bardia, M.; Calvet, T.; Dutilh, J.; Viladomat, F.; Codina, C.; Nair, J.J.; Zuanazzi, J.A.S.; Bastida, J. Crinine-type alkaloids from Hippeastrum aulicum and H. calyptratum. Phytochemistry 2014, 103, 188–195. [Google Scholar] [CrossRef]
- Sasidharan, S.; Chen, Y.; Saravanan, D.; Sundram, K.M.; Yoga Latha, L. Extraction, isolation and characterization of bioactive compounds from plants’ extracts. Afr. J. Tradit. Complement. Altern. Med. 2011, 8, 1–10. [Google Scholar] [CrossRef]
- Robles, M.A. Modified Dragendorff reagent for the procurement of lasting coloration of spots in paper chromatographic and electrophoretic investigation of alkaloids. Pharm. Weekbl. 1959, 94, 178–179. [Google Scholar]
- Singh, A.; Desgagné-Penix, I. Transcriptome and metabolome profiling of Narcissus pseudonarcissus ‘King Alfred’ reveal components of Amaryllidaceae alkaloid metabolism. Sci. Rep. 2017, 7, 17356. [Google Scholar] [CrossRef] [PubMed]
- Tallini, L.R.; Torras-Claveria, L.; Borges, W.S.; Kaiser, M.; Viladomat, F.; Zuanazzi, J.A.S.; Bastida, J. N-oxide alkaloids from Crinum amabile (Amaryllidaceae). Molecules 2018, 23, 1277. [Google Scholar] [CrossRef] [PubMed]
- Uzé, G.; Di Marco, S.; Mouchel-Vielh, E.; Monneron, D.; Bandu, M.-T.; Horisberger, M.A.; Dorques, A.; Lutfalla, G.; Mogensen, K.E. Domains of interaction between alpha interferon and its receptor components. J. Mol. Biol. 1994, 243, 245–257. [Google Scholar] [CrossRef]
- Fischl, W.; Bartenschlager, R. High-throughput screening using dengue virus reporter genomes. In Antiviral Methods and Protocols; Springer: Berlin/Heidelberg, Germany, 2013; pp. 205–219. [Google Scholar]
- He, J.; Chen, Y.; Farzan, M.; Choe, H.; Ohagen, A.; Gartner, S.; Busciglio, J.; Yang, X.; Hofmann, W.; Newman, W.; et al. CCR3 and CCR5 are co-receptors for HIV-1 infection of microglia. Nature 1997, 385, 645–649. [Google Scholar] [CrossRef]
- Shawky, E. Phytochemical and Biological Investigation of Clivia nobilis Flowers Cultivated in Egypt. Iran. J. Pharm. Res. IJPR 2016, 15, 531–535. [Google Scholar]
- Balouiri, M.; Sadiki, M.; Ibnsouda, S.K. Methods for in vitro evaluating antimicrobial activity: A review. J. Pharm. Anal. 2016, 6, 71–79. [Google Scholar] [CrossRef]





| Ring Type | Alkaloid | [M+] | B.P. | R.T. (min) | TIC (%) | Identification Source |
|---|---|---|---|---|---|---|
| Lycorine | Lycorine (1) | 287 | 226 | 25.902 | 5.9 | NIST 05 Database |
| 11,12-Dehydroanhydrolycorine (2) | 249 | 248 | 23.811 | 9.1 | [13] | |
| Crinine | Vittatine/Crinine (3a/3b) | 271 | 271 | 21.886 | 3.8 | NIST 05 Database |
| 8-O-Demethylmaritidine (4) | 273 | 273 | 22.275 | 15.4 | [35] | |
| Hamayne (5) | 287 | 258 | 25.321 | 39.1 | [36] | |
| Narciclasine | Trisphaeridine (6) | 223 | 223 | 19.022 | 5.0 | [13] |
| unknown | Unidentified (7) | 287 | 223 | 23.547 | 5.2 | n/a |
| unknown | Unidentified (8) | 279 | 278 | 27.682 | 16.4 | n/a |
Publisher’s Note: MDPI stays neutral with regard to jurisdictional claims in published maps and institutional affiliations. |
© 2021 by the authors. Licensee MDPI, Basel, Switzerland. This article is an open access article distributed under the terms and conditions of the Creative Commons Attribution (CC BY) license (https://creativecommons.org/licenses/by/4.0/).
Share and Cite
Ka, S.; Mérindol, N.; Seck, I.; Ricard, S.; Diop, A.; Boye, C.S.B.; Landelouci, K.; Daoust, B.; Berthoux, L.; Pépin, G.; et al. Biological Investigation of Amaryllidaceae Alkaloid Extracts from the Bulbs of Pancratium trianthum Collected in the Senegalese Flora. Molecules 2021, 26, 7382. https://doi.org/10.3390/molecules26237382
Ka S, Mérindol N, Seck I, Ricard S, Diop A, Boye CSB, Landelouci K, Daoust B, Berthoux L, Pépin G, et al. Biological Investigation of Amaryllidaceae Alkaloid Extracts from the Bulbs of Pancratium trianthum Collected in the Senegalese Flora. Molecules. 2021; 26(23):7382. https://doi.org/10.3390/molecules26237382
Chicago/Turabian StyleKa, Seydou, Natacha Mérindol, Insa Seck, Simon Ricard, Abdoulaye Diop, Cheikh Saad Bouh Boye, Karima Landelouci, Benoit Daoust, Lionel Berthoux, Geneviève Pépin, and et al. 2021. "Biological Investigation of Amaryllidaceae Alkaloid Extracts from the Bulbs of Pancratium trianthum Collected in the Senegalese Flora" Molecules 26, no. 23: 7382. https://doi.org/10.3390/molecules26237382
APA StyleKa, S., Mérindol, N., Seck, I., Ricard, S., Diop, A., Boye, C. S. B., Landelouci, K., Daoust, B., Berthoux, L., Pépin, G., Seck, M., & Desgagné-Penix, I. (2021). Biological Investigation of Amaryllidaceae Alkaloid Extracts from the Bulbs of Pancratium trianthum Collected in the Senegalese Flora. Molecules, 26(23), 7382. https://doi.org/10.3390/molecules26237382

